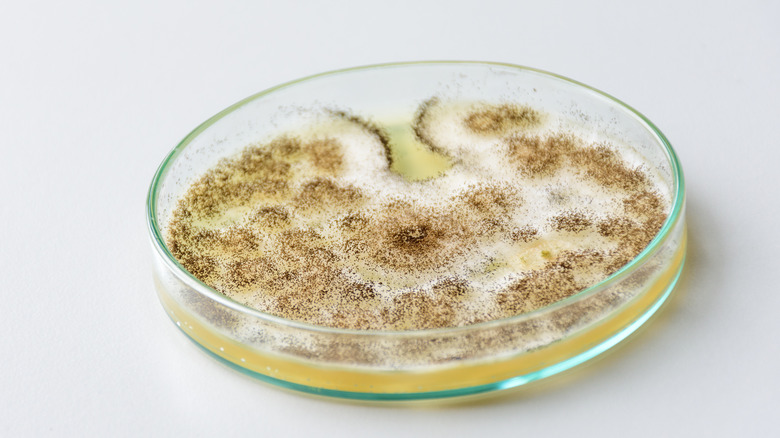

What Is Citric Acid And Is It Good For You?
If you sift through the non-flour products the King Arthur Baking Company offers on their website, you will find a 3.4-oz. jar of citric acid, also known as "sour salt," for $6.95. Citric acid, the product blurb describes, is a multitasker in the kitchen that can add a tang to your sourdough, delime your dishes as they undergo the travails of your dishwasher, curdle your milk into ricotta, and more!
The wide array of possible uses for citric acid also means that you can find it everywhere. But be not afraid, dear reader, for How Stuff Works explains that, despite having the word acid in its name, citric acid is simply the stuff that gushes out when you eat — guess what? — citrus fruits and other non-citric fruits, such as tomatoes. "Consuming foods with natural citric acid in them is completely healthy and should be part of your nutrition plan," James Hickey, a personal trainer and nutritionist, wrote in an email to How Stuff Works. "The only negative side effects that can happen is if you were to eat citric fruits in excess it can decrease the enamel on your teeth and cause heartburn." The Spruce Eats reports that manufactured citric acid has shown no benefits or harm.
So, in short, citric acid is a substance that naturally develops in certain fruits that benefits you with its antioxidants. The longer version, as you shall see in the next section, is that most of the citric acid you ingest comes not from a lemon, but a manufacturing process.
Making citric acid
In 1917, Charles Pfizer & Co — a small chemical company that would one day produce one of the primary vaccines for the coronavirus pandemic — was in the business of distilling citric acid from unripened fruits imported from Italy. However, according to the American Chemical Society, the World War had disrupted the supply line between Italy and the United States.
Needing a new way to produce citric acid, they made a gamble in hiring James Currie, who had plans on how to manufacture citric acid without needing citrus fruits. The fermentation of the moldy fungus Aspergillis niger, which is a black mold that afflicts fruits, converts sugars into citric acids. After a couple of years of trial and error, Currie's fermentation process outstripped the traditional way of rendering citric acid. Thus, it became the industry standard.
Biology Reader details the submerged culture fermentation in more depth. The mold is introduced to the culture contained in a bioreactor made of steel with various equipment to ensure a steady state of 30 C. After the citric acid ferments, the mixture goes through a series of processes in which it forms a precipitate of calcium citrate, and is subsequently filtered and treated with sulphuric acid. That mixture gets purified and put through a crystallization process after which the resulting liquid is dried, sieved, and packaged as the powdery citric acid sold by The King Arthur Baking Company.
It should be reemphasized here that, despite moldy origins, citric acid is safe for consumption.
Cooking with citric acid
As intimated at the beginning, citric acid is a veritable Swiss Army knife for cooking. Provided, that is, Swiss Army Knives have a primary purpose of providing a sour flavor profile. Citric acid is a particular tool to be put to a small set of particular ends, though those ends could be applied to many situations.
The reasons to use citric acid, per Eupicurious, are that it keeps your food looking nicer for longer and that it, in the words of Gordon Ramsay, "elevates" your dishes with a kick. In the first case, citric acid's antioxidant properties stop more temperamental foods and dishes, like apples and guacamole, from browning. So, you could make your meal beforehand without suffering from the disappointment that guests cannot see the wonder your work wrought.
As for the actual taste, MUNCHIES' senior editor Matthew Zuras told the publication that, "I use it when I want to add some tang to a dish but not additional liquid, like amping up the acid in a thick lemon curd or a compound butter, or when I'm making dry rubs and spice mixes."
That tang is also why citric acid appears as the first reason WIRED lists when the outlet revealed how Warheads candies destroyed the tongues of our youth. Citric acid activates our tongue's sour receptors with hydrogen ions, which is how it delivers the tang Zuras sometimes seeks.
Substituting citric acid
While citric acid is easily bought from pretty much anywhere, you might still want to have possible substitutions up your sleeve. The Eatist and The Eat Down suggest the same four ingredients you can use in a pinch if you find yourself lacking citric acid. Presumably, this is because citric acid is such a specific ingredient that substituting it doesn't quite work.
The first, unsurprisingly, is lemon juice. Lemons naturally produce citric acid, so you can use 4-5 tablespoons of lemon juice in place of a tablespoon of citric acid. That said, as lemon juice is a liquid ingredient, you would have to balance the other liquid ingredients accordingly. Next, you can use tartaric acid, which develops in grapes and bananas. While its powdered state signals that you would not have to alter the rest of the recipe, its sourness is more pronounced than citric acid's, so you should use half the amount of citric acid you would otherwise use.
The next two suggestions really scrape the bottom of the barrel. White distilled vinegar contains citric acid, but it is so weak you would need to triple the amount just to reach the right acidity. Doing so, however, would probably cause a lot of confusion when it comes to balancing the rest of the dish. The final substitution is vitamin C, which is an ascorbic acid.
While these would work if needed, you would be better off simply buying citric acid, or "sour salt," from your local grocer or supermarket.